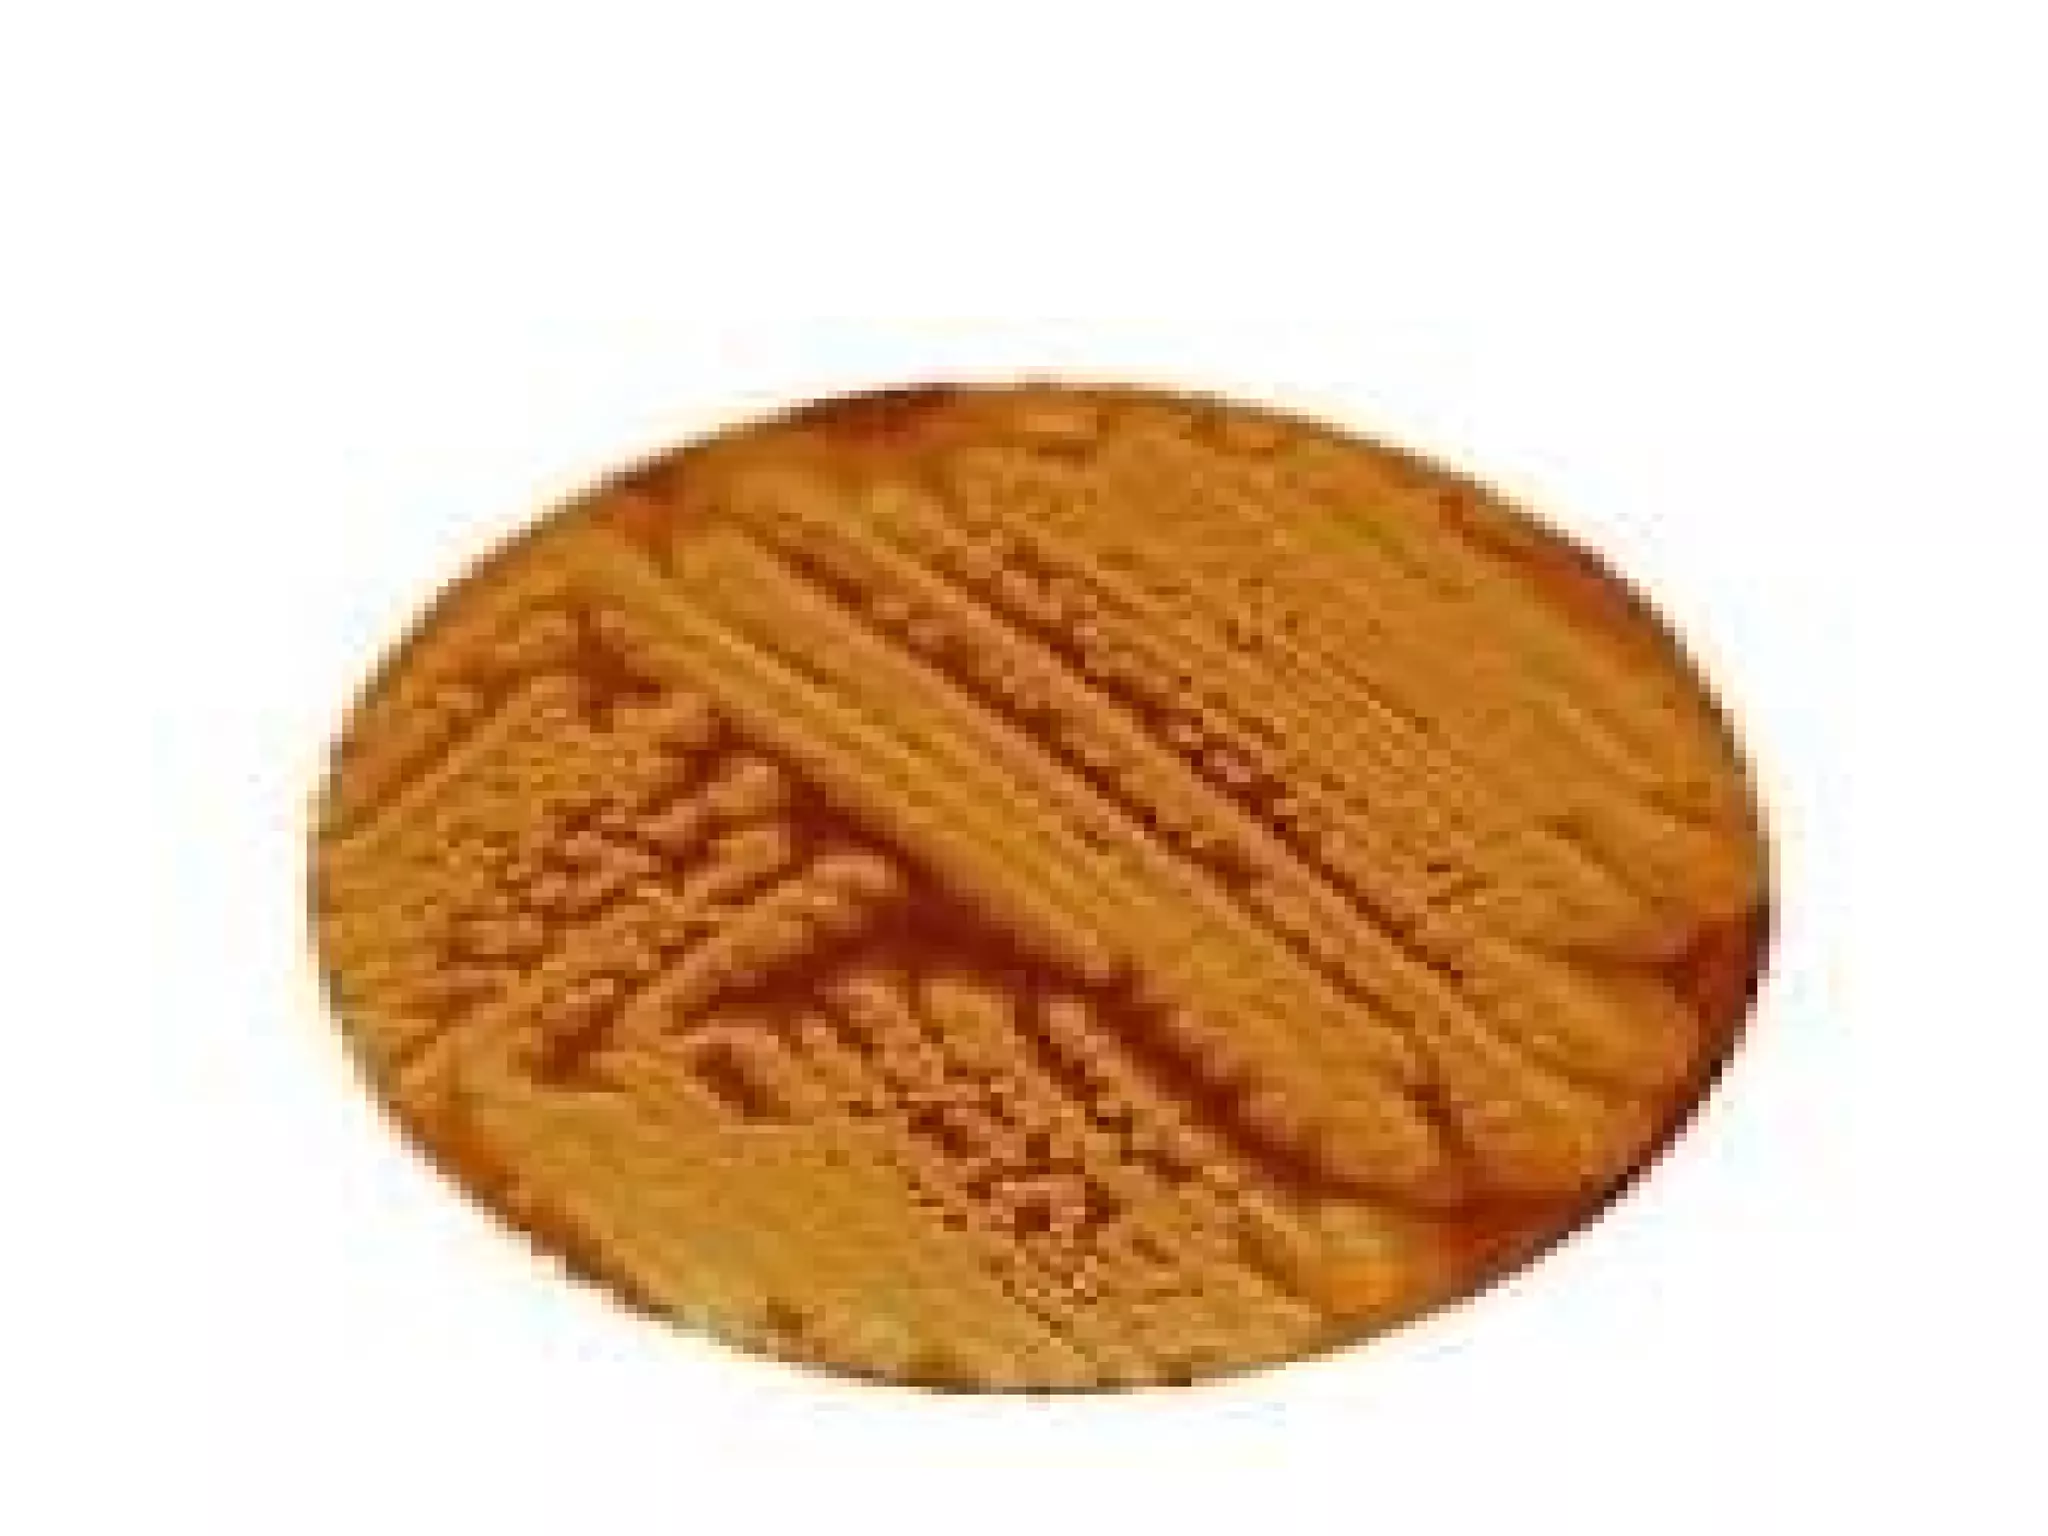
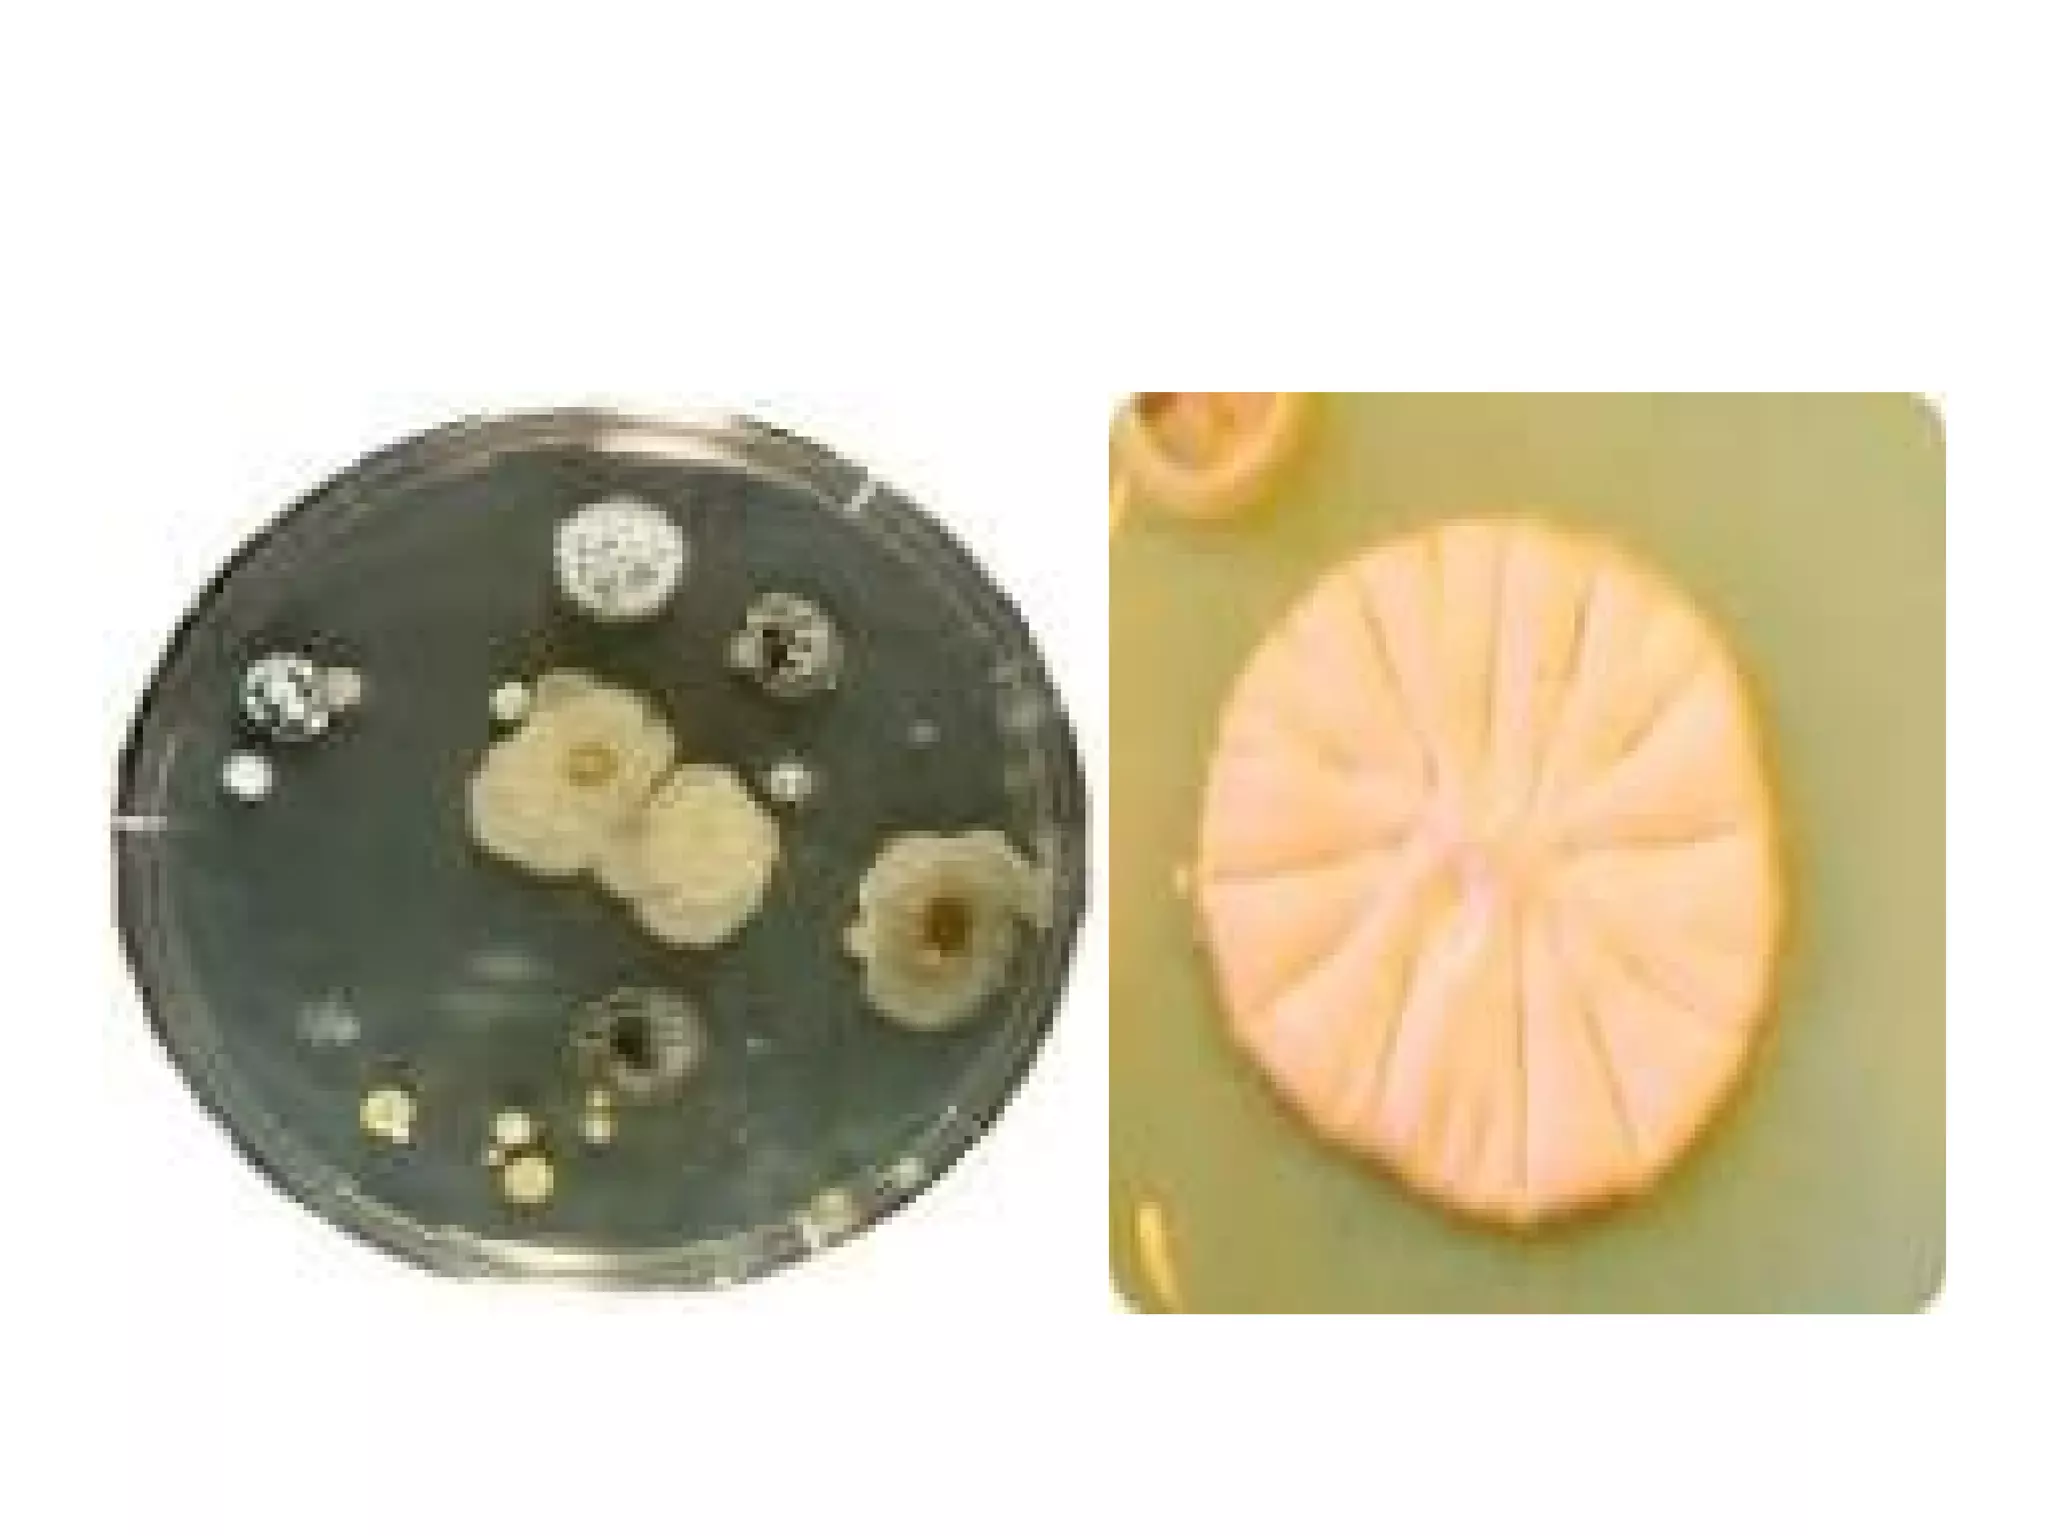
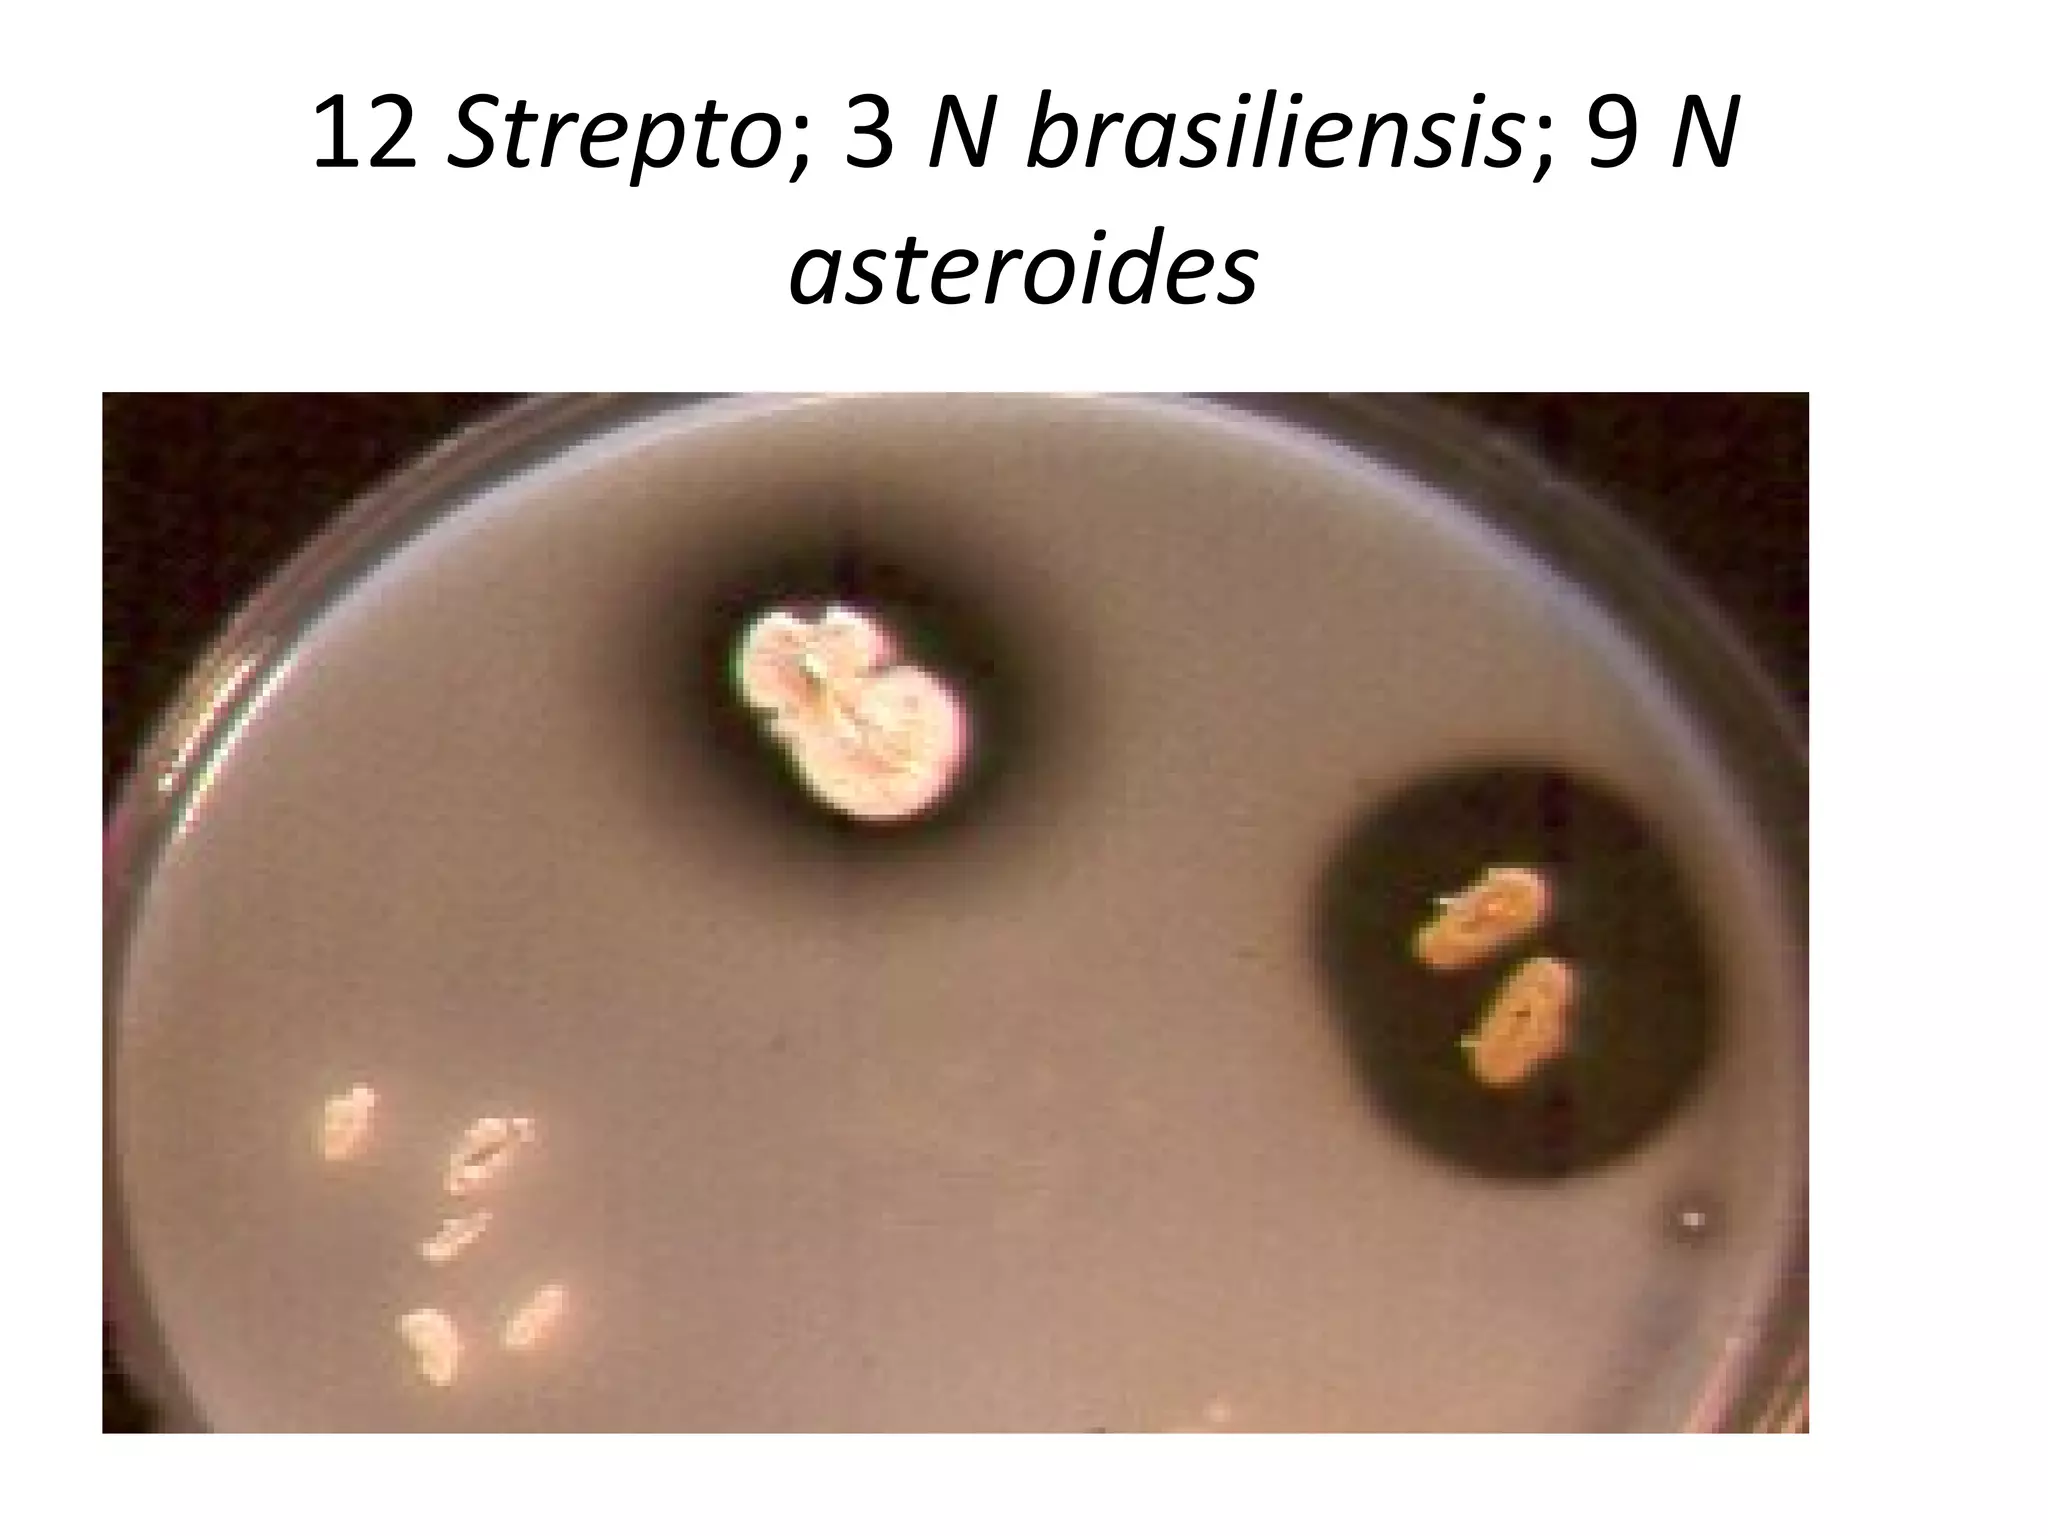
12 Strepto; 3 N brasiliensis; 9 N
asteroides
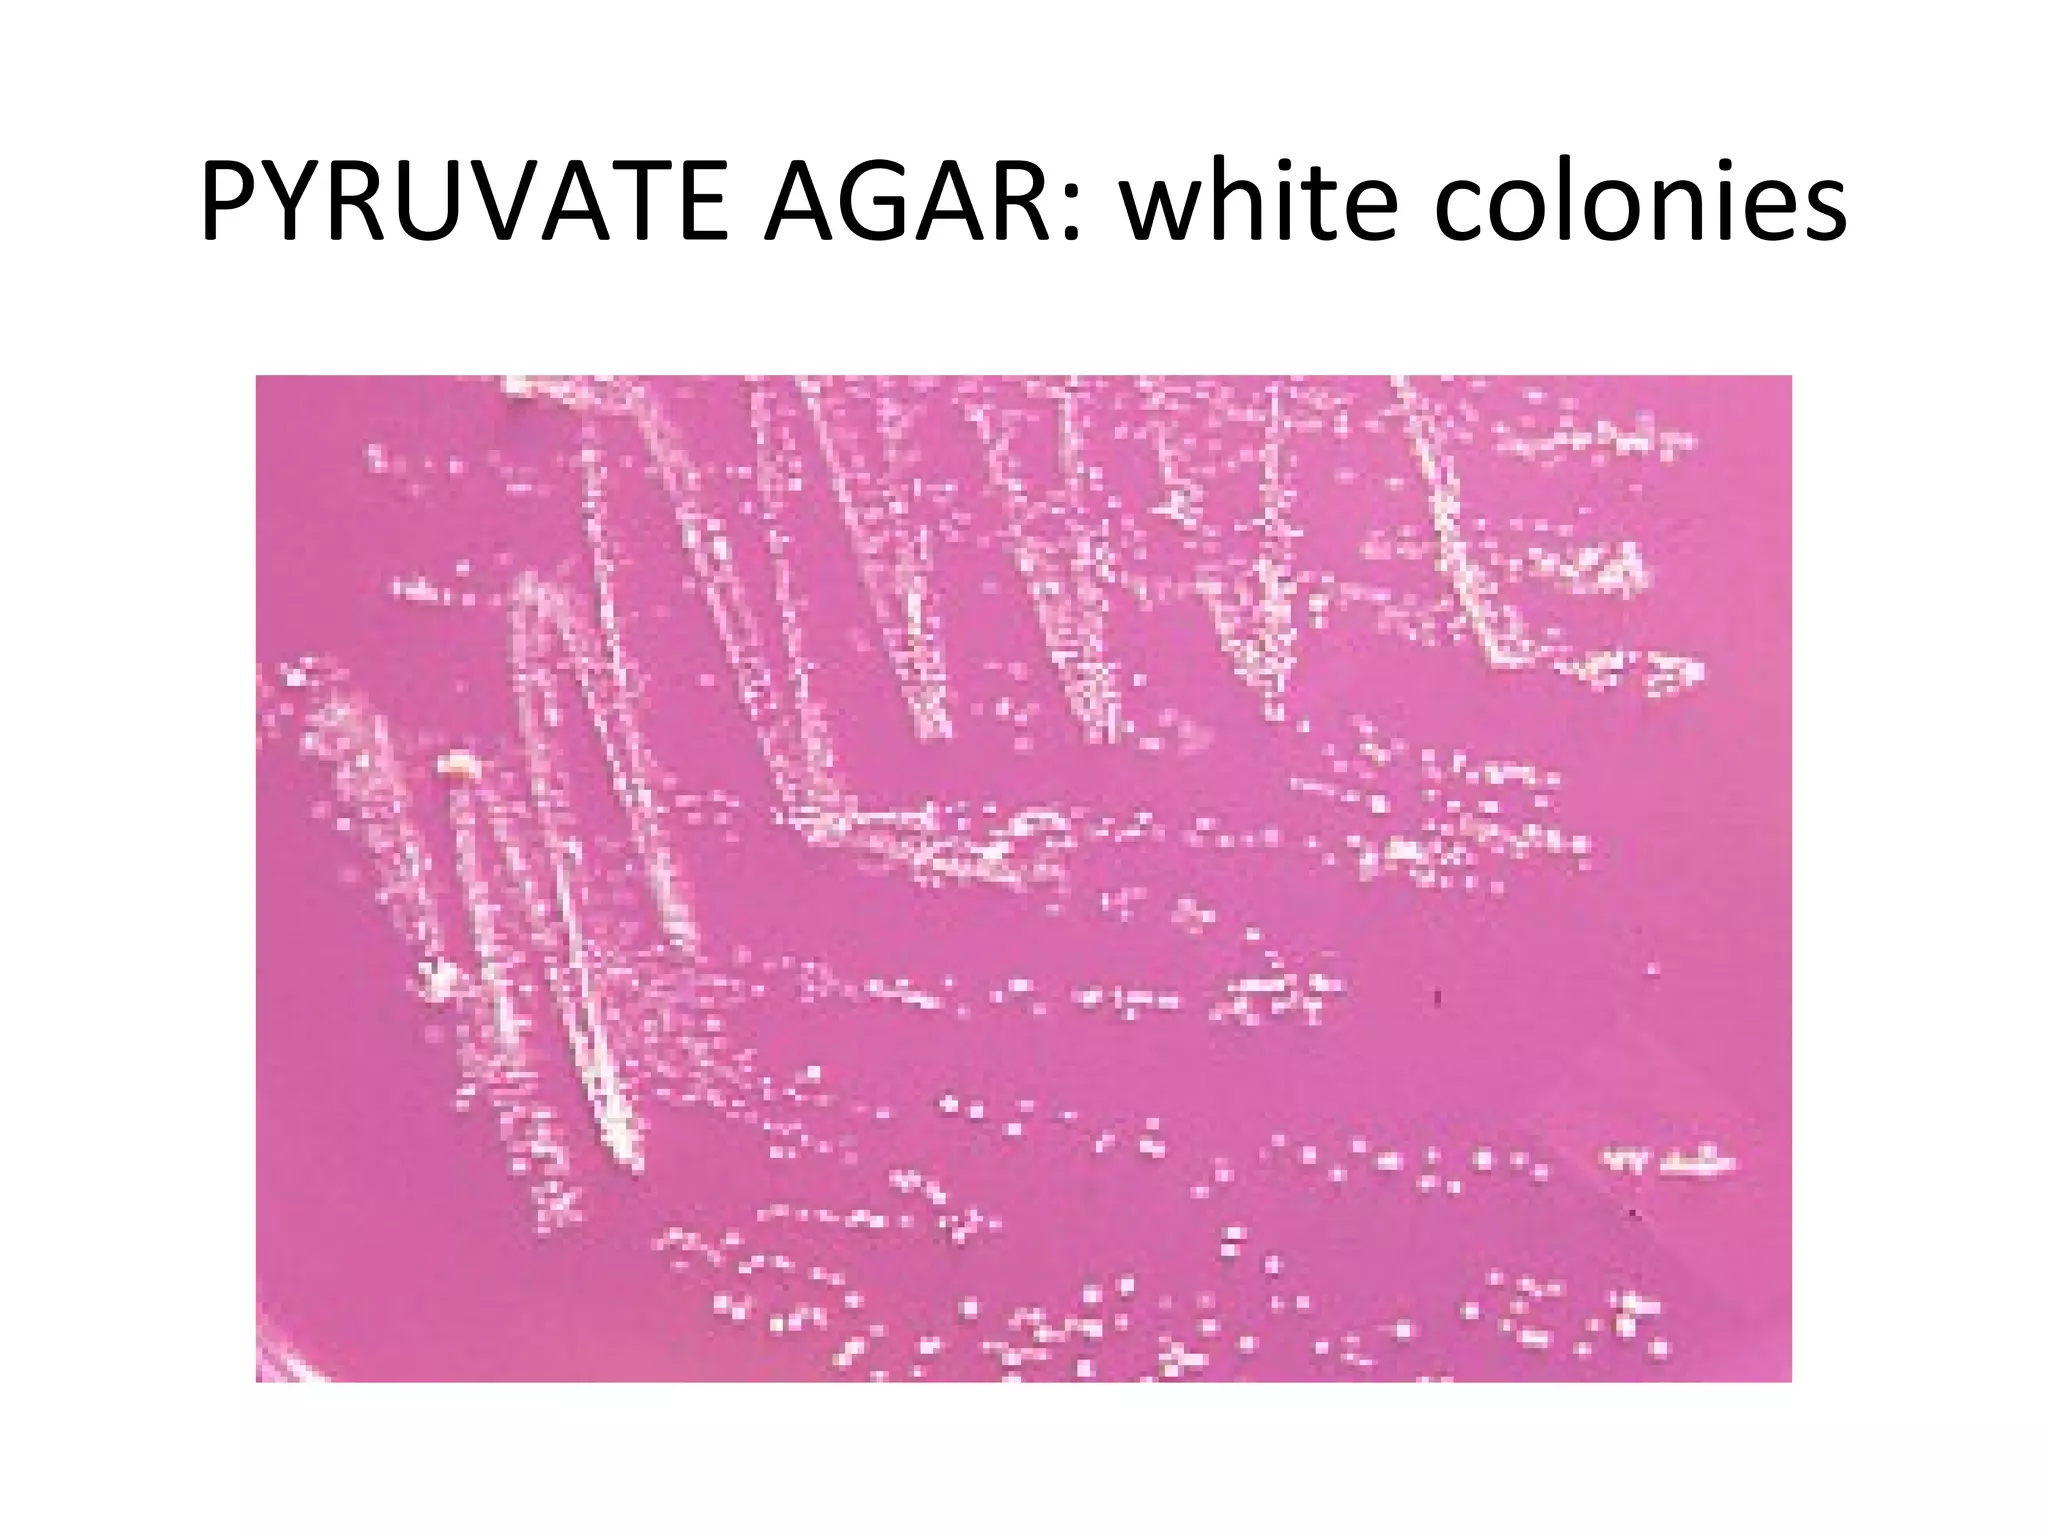
PYRUVATE AGAR: white colonies
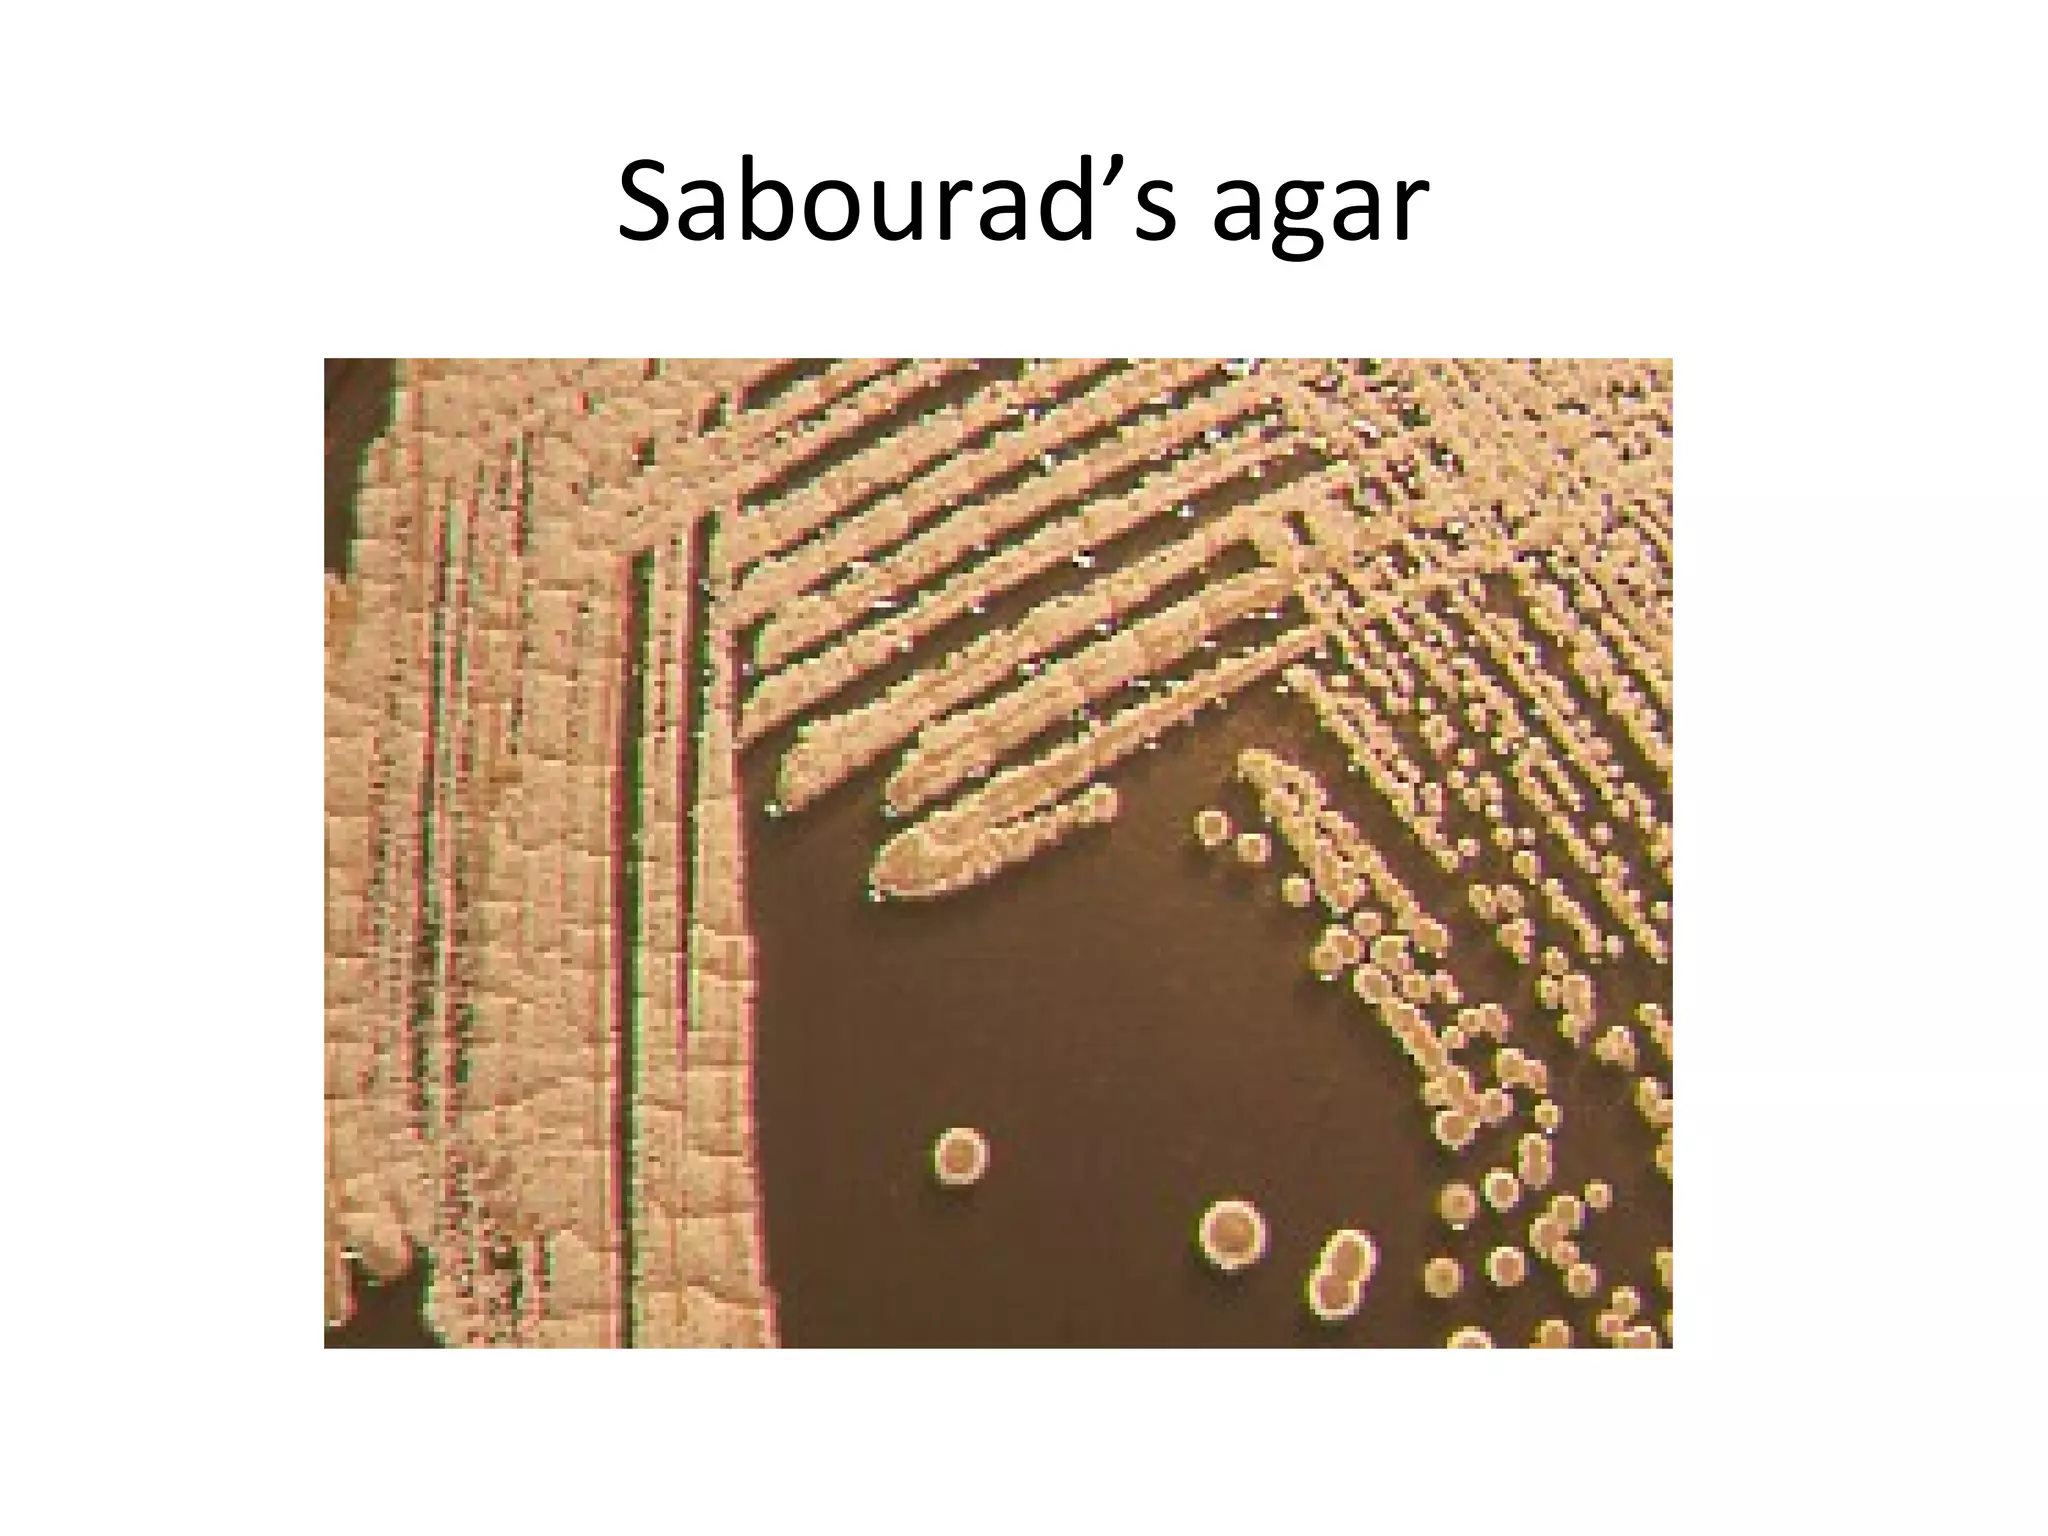
Sabourad’s agar
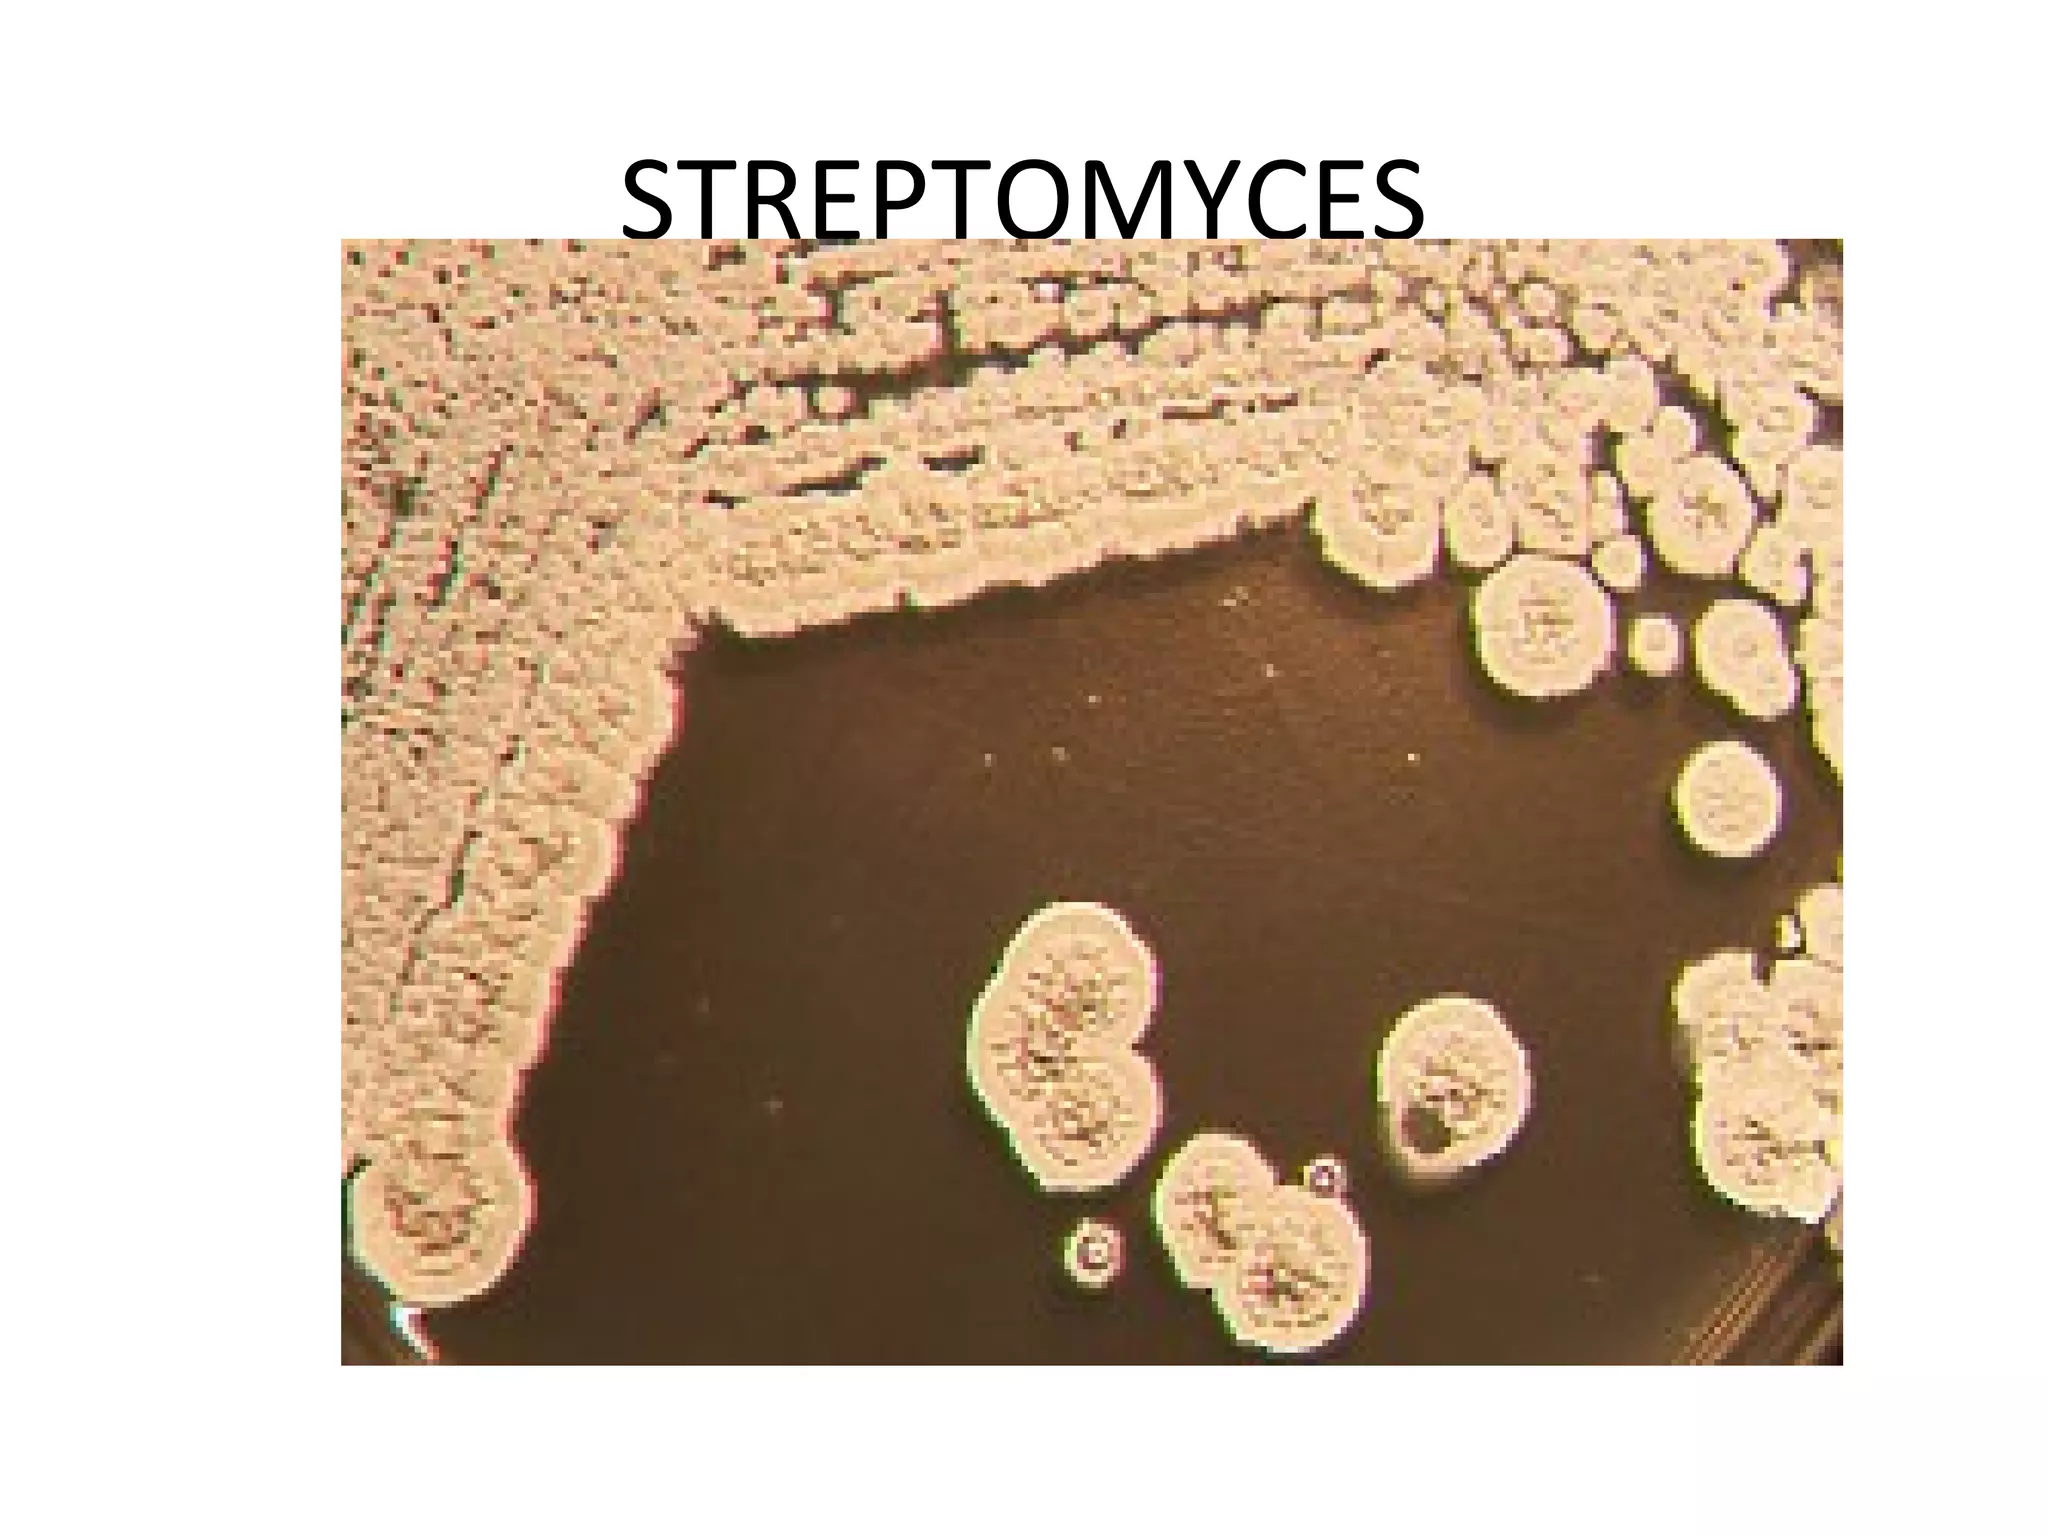
STREPTOMYCES

This document discusses the phylum Actinobacteria, focusing on the order Actinomycetales. Key points:
- Actinomycetales includes large, diverse Gram-positive bacilli that form chains or filaments. They are found worldwide, especially in soil and aquatic environments, and play roles in decomposition, antibiotic production, and occasionally pathogenesis.
- Genera discussed include Streptomyces, Nocardia, Rhodococcus, Corynebacterium, and Mycobacterium. Nocardia can cause opportunistic infections in immunocompromised individuals.
- Characteristics include aerobic growth, branching filaments, and high G+C DNA content. Colonies of